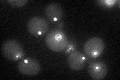
YLR212C
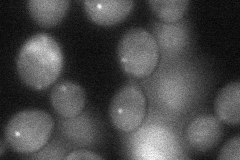
YLR212C
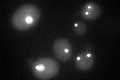
YLR212C

View description
Gamma-tubulin, involved in nucleating microtubules from both the cytoplasmic and nuclear faces of the spindle pole body
Localization:
Intensity:
Fold change:
Significance:
-
C’ GFP library in SD
punctate32.29 -
N' NOP1pr-GFP in SD

punctate75.2866 -
N' TEF2pr-mCherry in SD

punctate,nucleus118.475 -
N' NATIVEpr-GFP in SD

punctate33.9481 -
N' TEF2pr-VC and Cyto-VN in SD
punctate42.1154 -
C’ GFP library in SD+DTT
punctate33.641.04No -
C’ GFP library in SD+H2O2

punctate29.390.91No -
C’ GFP library in Starvation Media

punctate32.951.02No -
C’ GFP library on the background of Pup2-DaMP

punctate -
C’ GFP library on the background of CCT mutant

punctate47.97551.48517Yes
